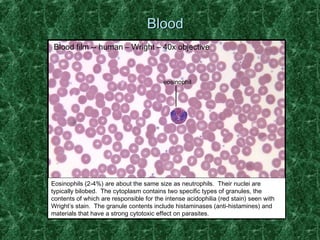
BBlloooodd 
Blood film -- human – Wright – 40x objective 
eosinophil 
Eosinophils (2-4%) are about the same size as neutrophils. Their nuclei are 
typically bilobed. The cytoplasm contains two specific types of granules, the 
contents of which are responsible for the intense acidophilia (red stain) seen with 
Wright’s stain. The granule contents include histaminases (anti-histamines) and 
materials that have a strong cytotoxic effect on parasites.
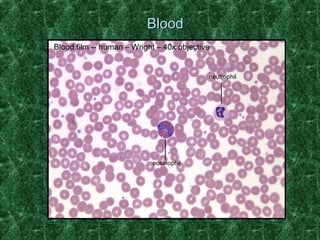
BBlloooodd 
Blood film -- human – Wright – 40x objective 
neutrophil 
eosinophil
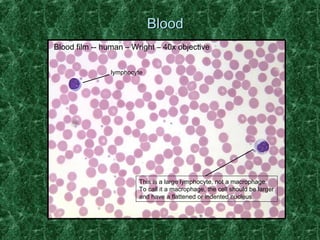
BBlloooodd 
Blood film -- human – Wright – 40x objective 
lymphocyte 
This is a large lymphocyte, not a macrophage. 
To call it a macrophage, the cell should be larger 
and have a flattened or indented nucleus.

The document provides a histological review of human blood, detailing various blood cell types observed in a Wright-stained blood film. It describes neutrophils, eosinophils, basophils, monocytes, and lymphocytes, highlighting their sizes, functions, and identifying characteristics. Each cell type is associated with specific roles in immune response and blood functions.